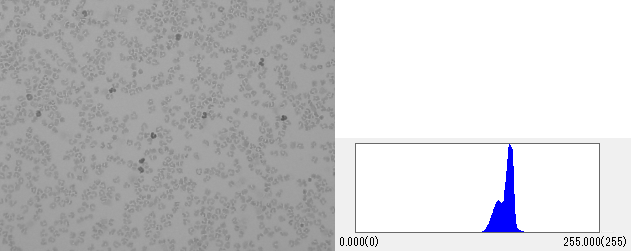

画像処理
輝度値のヒストグラム - 画像の性質を見てみよう
輝度値のヒストグラム
輝度値とは、画素が持つ明るさの値となります。画像はもともと『画素』という小さいつぶつぶの集まりで、各々の画素が輝度値の情報を持っています。
(関連記事:『2値化 - 画像解析の基本処理、対象を検出する』)
画像の輝度値は、8bitであれば0~255で示されるので、最小が0、最大が255となることが一般的です。
また、ヒストグラムとは、縦軸に度数、横軸に階級をとるグラフで、データがどのように分布しているか視覚的に捉えることができます。
画像の性質を表すポピュラーな方法として、このヒストグラムを使う方法があります。
これは横軸を輝度値、縦軸をその輝度値が画像上に出現する頻度としてグラフ化することを示しています。
画像処理、画像解析では非常に重要な考え方で、ヒストグラムを確認すると明るさの分布を可視化できるためその画像が持っている特徴をおおよそ把握することができます。
ここでは実際にいくつかの画像から、その画像がどんなヒストグラムを描くのかを一緒にみてみたいと思います。
実例は分かりやすいモノクロ画像で示しますが、RGBそれぞれに対してヒストグラムがあるだけでカラー画像でも考え方は一緒です。
暗い画像のヒストグラム

画像はデジタルカメラで工業部品を撮影した画像です。画像全体が暗く、描かれるヒストグラムが全体的に左側(輝度値 0 側)に寄っていて、画像全体で暗い画素が多いことが分かります。
このような画像には明るさやコントラストの改善が必要です。
明るい画像のヒストグラム

次は同じ対象を照明を強くして撮影した画像です。
描かれるヒストグラムが全体的に右側(輝度値 255 側)に寄っていて、画像全体で明るい画素が多いことが分かります。
照明が強すぎてハレーションを起こしているなど、被写体に適した状態な画像ではない状態になっていることが多いため暗すぎる場合と同様に明るさの改善が必要です。
コントラストが低い画像
画像は顕微鏡で細胞を撮影した画像です。
ヒストグラムは横幅の分布が狭く、ある範囲に集中しています。このような画像は全体的に明暗の差が無いコントラストが分かりづらい画像といえます。コントラストの調整を行うと見やすく、解析しやすくなる画像といえます。
対象と背景が明確に分かれている画像

このようにヒストグラムの範囲は広く、ヒストグラム中に特徴的な凸が複数個所見られるような画像は背景と対象物が明確に分かれた画像といえます。
画像解析でも「粒子の数を数える」「粒子の大きさを測る」といったニーズにはこのような画像が非常に適しています。
背景と対象物の部分に輝度値でわける2値化処理が非常に行いやすいためです。
一般的な人物写真

最後に画像処理について調べたことのある方は必ず1度は出会ったことがあるはずの"レナ"の画像のヒストグラムを見てみましょう。
ヒストグラムの幅も広く、明るすぎたり暗すぎたりといった傾向もないそんな傾向が見られます。
顕微鏡写真などではこういった傾向を示すものは少ないですが、一般的な人物写真などはこのような傾向を示すことが多いです。
RGB色情報のコントラスト比較
最後に、画像解析ソフトウェアWinROOFでレナの画像をRGBそれぞれの色情報に分離してヒストグラムを観察してみました。
以前から赤みが強いとは思っていましたが、ここまで傾向に差があったとは...
(左からRGBの順に並べています)

ヒストグラムにて明るさの分布傾向を把握することで、それぞれの画像の特徴を理解いただけたと思います。
さらに理解を深めたい方は、応用編の記事
(明るさの補正 - ヒストグラムと明るさの関係))
をご覧ください。
また、実際にヒストグラムを見たい方向けに、WinROOFシリーズの無料体験版(デモ版)も用意しています。
気になる方は下のリンクからダウンロードしてみてくださいね。
デモ版をダウンロードするにはこちらをクリック!










